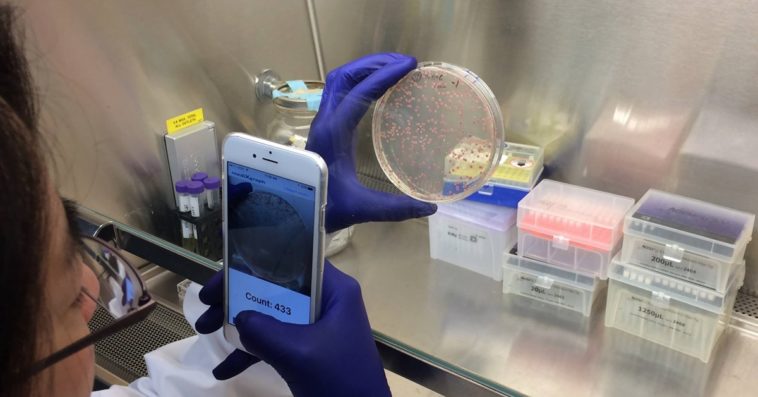
Cfu Scope Cover

สำหรับคนที่เรียนหรือทำงานในวงการจุลชีววิทยา อาจมีความเจ็บปวดกับการนั่งนับจํานวนโคโลนี CFU (colony-forming units) และในวันนี้เราก็จะมาแนะนำแอปพลิเคชันเล็ก ๆ บนไอโฟนที่จะช่วยให้ทั้งนักศึกษา และคนที่ทำงานในวงการมีความสะดวกมากยิ่งขึ้น

CFU Scope
สำหรับแอปพลิเคชันนี้พัฒนาขึ้นโดย Medixgraph และก็ไม่เพียงแค่ CFU Scope แต่ยังมี Grid CFU Scope รวมถึงแอปพลิเคชันใหม่ล่าสุดอย่าง ClearFace ซึ่งใช้ AI ในการวิเคราะห์ผิวหน้าและสภาพสิว (ซึ่งเราจะมารีวิวกันในวันหลัง) แต่สำหรับใครที่ต้องการผู้ช่วยในการนับจํานวนโคโลนี สามารถดาวน์โหลดได้จากด้านล่างเลย
- ดาวน์โหลด : CFU Scope
ที่มา – medixgraph